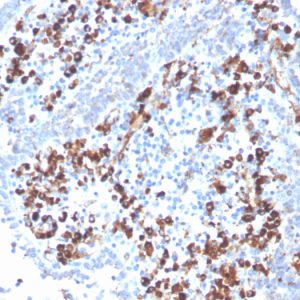

CD5 antigen-like, Apoptosis inhibitor expressed by macrophages, CT-2, IgM-associated peptide, SP-alpha, AAC-11; AIM; API6; APOPTOSIS INHIBITOR 6; APOPTOSIS INHIBITOR OF MACROPHAGES; CD5 antigen like (scavenger receptor cysteine rich family); CD5 antigen-like; CT-2; Highly similar to ANTIGEN WC1.1 [Bos taurus]; IgM-associated peptide; Pdp; PRO229; SCAVENGER RECEPTOR CYSTEINE-RICH FAMILY; SP-alpha; Spalpha
Apoptosis, Autophagy, Breast Cancer, Cancer, Cardiovascular, Cell Biology, Cellular Markers and Tags, Developmental Biology, Endocrine, Epigenetics, Gastrointestinal Tract, Hypoxia, Immuno Oncology, Immunology, Kidney, Lymphatic, Metabolism, Microbiology, Muscle, Neuroscience, Pancreatic Cancer, Prostate Cancer, Skin, Stem Cell, AKT Signaling, Angiogenesis, Articular Cartilage Extracellular Matrix, B Cell Markers, Basal Cell Marker, BBB VCAM-1 Signaling, Bladder Cancer, Cardiac Stem Cells, Colon Cancer, Colorectal Cancer, Complement System, CTLA-4 blockade immunotherapy, Cytokine Signaling, Defective Intrinsic Apoptosis, Dendritic Cell Marker, Digestion, Endothelial Cell Marker, Hematopoietic Stem Cells, Immune checkpoint, Infectious Disease, Lipid Metabolism, Lung Cancer, MAPK Signaling, Mast Cell Marker, Melanoma, Mesenchymal Stem Cell Differentiation, Mitochondria Marker, Neural Stem Cells, Neuroinflammation, Nuclear Marker, Oncology, Ovarian Cancer, PD-1 blockade immunotherapy, Signal Transduction, Stem Cell Differentiation, Transcription Factors
Showing all 2 results

Showing all 2 results